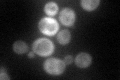
YJR109C
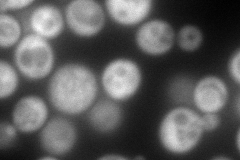
YJR109C
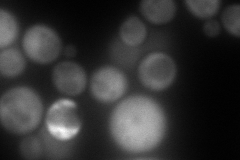
YJR109C
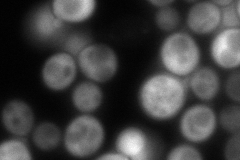
YJR109C
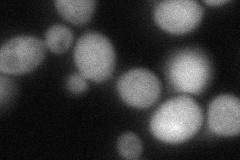
YJR109C
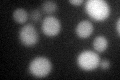
YJR109C

View description
Large subunit of carbamoyl phosphate synthetase, which catalyzes a step in the synthesis of citrulline, an arginine precursor
Localization:
Intensity:
Fold change:
Significance:
-
C’ GFP library in SD
cytosol66.03 -
N' NOP1pr-GFP in SD
cytosol255.216 -
N' TEF2pr-mCherry in SD
cytosol210.335 -
N' NATIVEpr-GFP in SD
cytosol223.039 -
N' TEF2pr-VC and Cyto-VN in SD
cytosol73.3164 -
C’ GFP library in SD+DTT
cytosol29.610.44Yes -
C’ GFP library in SD+H2O2

cytosol80.751.22No -
C’ GFP library in Starvation Media

cytosol23.670.35No -
C’ GFP library on the background of Pup2-DaMP

cytosol -
C’ GFP library on the background of CCT mutant

cytosol66.84171.01205No
